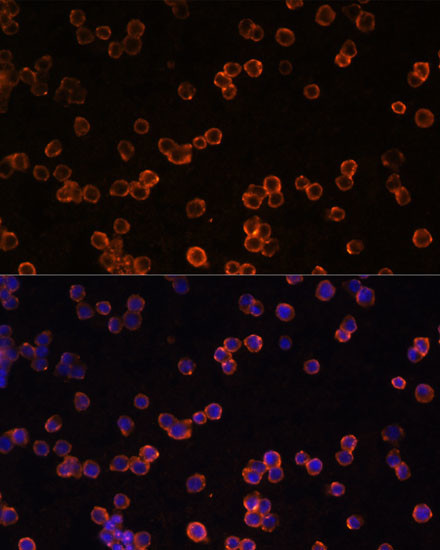
CD39 Antibody in Immunocytochemistry (ICC/IF)

Search
Invitrogen
CD39 Polyclonal Antibody
{{$productOrderCtrl.translations['antibody.pdp.commerceCard.promotion.promotions']}}
{{$productOrderCtrl.translations['antibody.pdp.commerceCard.promotion.viewpromo']}}
{{$productOrderCtrl.translations['antibody.pdp.commerceCard.promotion.promocode']}}: {{promo.promoCode}} {{promo.promoTitle}} {{promo.promoDescription}}. {{$productOrderCtrl.translations['antibody.pdp.commerceCard.promotion.learnmore']}}




Please note: We are reviewing Western blot images included in the antibody testing data in our catalog, including those provided by third parties. Unless expressly labeled or annotated as “raw-unedited”, Western blot images included in the antibody testing data in our catalog may have been edited, optimized or otherwise adjusted for presentation.
产品信息
PA5-86969
种属反应
宿主/亚型
分类
类型
抗原
偶联物
形式
浓度
规格
纯化类型
保存液
内含物
保存条件
运输条件
RRID
产品详细信息
Purity is > 95% by SDS-PAGE.
靶标信息
CD39 is an integral membrane protein characterized by two transmembrane domains and forms a homotetramer structure. It is recognized as the most prominent ectoenzyme within the immune system, primarily functioning to remove toxic extracellular ATP by converting it into ADP or AMP. CD39 works in conjunction with CD73 to hydrolyze ATP and is well characterized on Langerhans cells. Originally identified on activated lymphocytes, CD39 is expressed on a variety of immune cells, including peripheral blood B cells, monocytes, and T cell clones. It is also found on a subset of T cells, B cells, and dendritic cells, with weaker expression observed on monocytes and granulocytes. The CD39 cell surface antigen is a 70-100kD molecule, and its expression is induced on T cells and increases on B cells as a late activation antigen. CD39 possesses intrinsic ecto-ATPase activity, playing a crucial role in modulating extracellular nucleotide levels and contributing to immune regulation.
仅用于科研。不用于诊断过程。未经明确授权不得转售。
篇参考文献 (0)
生物信息学
蛋白别名: ATP diphosphohydrolase; ATP-DPH; ATPDase; CD39; DKFZp686D194; DKFZp686I093; Ecto-apyrase; Ecto-ATP diphosphohydrolase 1; ecto-ATPase 1; Ecto-ATPDase 1; Ectonucleoside triphosphate diphosphohydrolase 1; FLJ40921; FLJ40959; Lymphoid cell activation antigen; NTPDase 1; NTPDase1; Nucleoside triphosphate diphosphohydrolase 1
基因别名: 2610206B08Rik; AA408691; CD39; ENTPD1; NTPDase-1
UniProt ID: (Mouse) P55772
Entrez Gene ID: (Mouse) 12495, (Rat) 64519